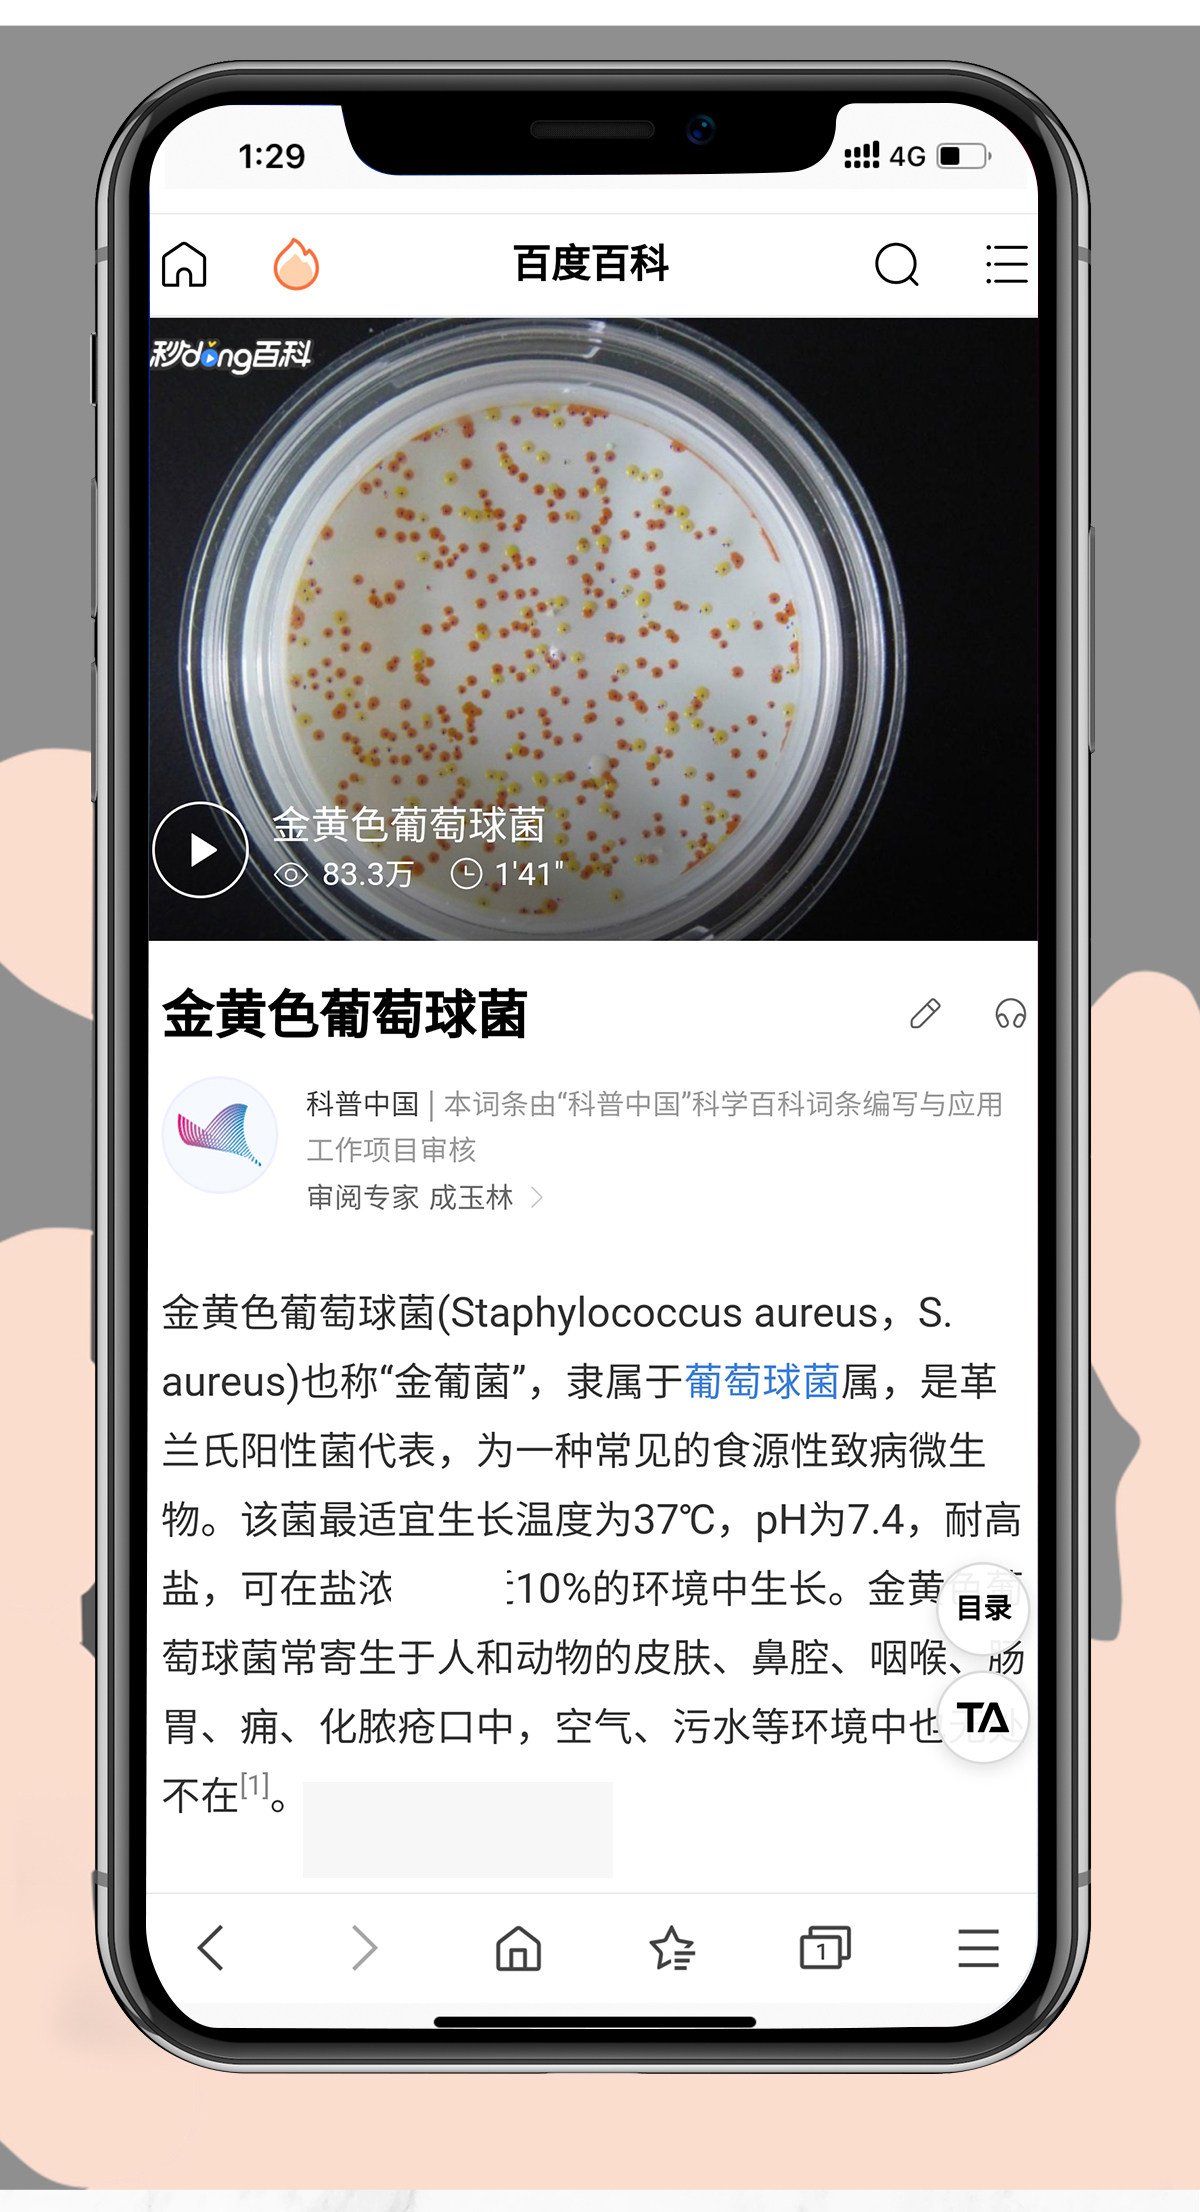

Незащитный горшок с силиконовой лопатой Дом с жареными устойчивостью к лопату Высокая температура силиконовая шпатель

Цена: 2 494-3 698руб. (¥118)
Артикул: 628180594695
Вес товара: ~0.7 кг. Указан усредненный вес, который может отличаться от фактического. Не включен в цену, оплачивается при получении.
Описание товараPHA+PGltZyBzcmM9Imh0dHBzOi8vaW1nLmFsaWNkbi5jb20vaW1nZXh0cmEvaTIvMjIwMTQ4NDYwMjQ0Ny9PMUNOMDFjZ2VjRnUxVHdsblV0aGZGYl8hITIyMDE0ODQ2MDI0NDcuanBnIiBhbGlnbj0iYWJzbWlkZGxlIj48aW1nIHNyYz0iaHR0cHM6Ly9pbWcuYWxpY2RuLmNvbS9pbWdleHRyYS9pMy8yMjAxNDg0NjAyNDQ3L08xQ04wMVRjdFlFWTFUd2xuV3dvTlRvXyEhMjIwMTQ4NDYwMjQ0Ny5qcGciIGFsaWduPSJhYnNtaWRkbGUiPjxpbWcgc3JjPSJodHRwczovL2ltZy5hbGljZG4uY29tL2ltZ2V4dHJhL2k0LzIyMDE0ODQ2MDI0NDcvTzFDTjAxMnJOaEtjMVR3bG5aYnZGQmxfISEyMjAxNDg0NjAyNDQ3LmpwZyIgYWxpZ249ImFic21pZGRsZSI+PGltZyBzcmM9Imh0dHBzOi8vaW1nLmFsaWNkbi5jb20vaW1nZXh0cmEvaTMvMjIwMTQ4NDYwMjQ0Ny9PMUNOMDFKV0tDUWMxVHdsblVrQTBLS18hITIyMDE0ODQ2MDI0NDcuanBnIiBhbGlnbj0iYWJzbWlkZGxlIj48aW1nIHNyYz0iaHR0cHM6Ly9pbWcuYWxpY2RuLmNvbS9pbWdleHRyYS9pMy8yMjAxNDg0NjAyNDQ3L08xQ04wMXBBRFpoYTFUd2xuVWtDVUJ5XyEhMjIwMTQ4NDYwMjQ0Ny5qcGciIGFsaWduPSJhYnNtaWRkbGUiPjxpbWcgc3JjPSJodHRwczovL2ltZy5hbGljZG4uY29tL2ltZ2V4dHJhL2k0LzIyMDE0ODQ2MDI0NDcvTzFDTjAxQ1FHYXA3MVR3bG5XZERSZlBfISEyMjAxNDg0NjAyNDQ3LmpwZyIgYWxpZ249ImFic21pZGRsZSI+PGltZyBzcmM9Imh0dHBzOi8vaW1nLmFsaWNkbi5jb20vaW1nZXh0cmEvaTIvMjIwMTQ4NDYwMjQ0Ny9PMUNOMDFzNkdZV0cxVHdsbllSa3ZyYV8hITIyMDE0ODQ2MDI0NDcuanBnIiBhbGlnbj0iYWJzbWlkZGxlIj48aW1nIHNyYz0iaHR0cHM6Ly9pbWcuYWxpY2RuLmNvbS9pbWdleHRyYS9pMy8yMjAxNDg0NjAyNDQ3L08xQ04wMXQwZ2MzYTFUd2xuVWtDVUNmXyEhMjIwMTQ4NDYwMjQ0Ny5qcGciIGFsaWduPSJhYnNtaWRkbGUiPjxpbWcgc3JjPSJodHRwczovL2ltZy5hbGljZG4uY29tL2ltZ2V4dHJhL2k0LzIyMDE0ODQ2MDI0NDcvTzFDTjAxMVpuTW9TMVR3bG5RYzdPNkJfISEyMjAxNDg0NjAyNDQ3LmpwZyIgYWxpZ249ImFic21pZGRsZSI+PGltZyBzcmM9Imh0dHBzOi8vaW1nLmFsaWNkbi5jb20vaW1nZXh0cmEvaTEvMjIwMTQ4NDYwMjQ0Ny9PMUNOMDE5SG1HcUgxVHdsblVrOThLMV8hITIyMDE0ODQ2MDI0NDcuanBnIiBhbGlnbj0iYWJzbWlkZGxlIj48aW1nIHNyYz0iaHR0cHM6Ly9pbWcuYWxpY2RuLmNvbS9pbWdleHRyYS9pMi8yMjAxNDg0NjAyNDQ3L08xQ04wMWtwc0lQSDFUd2xuVURDWXdvXyEhMjIwMTQ4NDYwMjQ0Ny5qcGciIGFsaWduPSJhYnNtaWRkbGUiPjxpbWcgc3JjPSJodHRwczovL2ltZy5hbGljZG4uY29tL2ltZ2V4dHJhL2k0LzIyMDE0ODQ2MDI0NDcvTzFDTjAxMzNkdU9vMVR3bG5VOUZxbmtfISEyMjAxNDg0NjAyNDQ3LmpwZyIgYWxpZ249ImFic21pZGRsZSI+PGltZyBzcmM9Imh0dHBzOi8vaW1nLmFsaWNkbi5jb20vaW1nZXh0cmEvaTMvMjIwMTQ4NDYwMjQ0Ny9PMUNOMDE4U3N6c2oxVHdsblVrQ2NaSF8hITIyMDE0ODQ2MDI0NDcuanBnIiBhbGlnbj0iYWJzbWlkZGxlIj48aW1nIHNyYz0iaHR0cHM6Ly9pbWcuYWxpY2RuLmNvbS9pbWdleHRyYS9pNC8yMjAxNDg0NjAyNDQ3L08xQ04wMUZBbFBIRTFUd2xuVUQ5YzBmXyEhMjIwMTQ4NDYwMjQ0Ny5qcGciIGFsaWduPSJhYnNtaWRkbGUiPjxpbWcgc3JjPSJodHRwczovL2ltZy5hbGljZG4uY29tL2ltZ2V4dHJhL2kyLzIyMDE0ODQ2MDI0NDcvTzFDTjAxMDdub3ZnMVR3bG5Xd3B6TXRfISEyMjAxNDg0NjAyNDQ3LmpwZyIgYWxpZ249ImFic21pZGRsZSI+PGltZyBzcmM9Imh0dHBzOi8vaW1nLmFsaWNkbi5jb20vaW1nZXh0cmEvaTIvMjIwMTQ4NDYwMjQ0Ny9PMUNOMDFzeWxTQzYxVHdsblFjOU9zY18hITIyMDE0ODQ2MDI0NDcuanBnIiBhbGlnbj0iYWJzbWlkZGxlIj48aW1nIHNyYz0iaHR0cHM6Ly9pbWcuYWxpY2RuLmNvbS9pbWdleHRyYS9pMi8yMjAxNDg0NjAyNDQ3L08xQ04wMUJWQm9HUzFUd2xuVnl2NkxMXyEhMjIwMTQ4NDYwMjQ0Ny5qcGciIGFsaWduPSJhYnNtaWRkbGUiPjxpbWcgc3JjPSJodHRwczovL2ltZy5hbGljZG4uY29tL2ltZ2V4dHJhL2k0LzIyMDE0ODQ2MDI0NDcvTzFDTjAxNXU1NHR3MVR3bG5VRERBUVBfISEyMjAxNDg0NjAyNDQ3LmpwZyIgYWxpZ249ImFic21pZGRsZSI+PGltZyBzcmM9Imh0dHBzOi8vaW1nLmFsaWNkbi5jb20vaW1nZXh0cmEvaTIvMjIwMTQ4NDYwMjQ0Ny9PMUNOMDFsWVNYSW4xVHdsblV0aFNwaV8hITIyMDE0ODQ2MDI0NDcuanBnIiBhbGlnbj0iYWJzbWlkZGxlIj48aW1nIHNyYz0iaHR0cHM6Ly9pbWcuYWxpY2RuLmNvbS9pbWdleHRyYS9pNC8yMjAxNDg0NjAyNDQ3L08xQ04wMUdTWk1TaTFUd2xuWmJ1bTdvXyEhMjIwMTQ4NDYwMjQ0Ny5qcGciIGFsaWduPSJhYnNtaWRkbGUiPjxpbWcgc3JjPSJodHRwczovL2ltZy5hbGljZG4uY29tL2ltZ2V4dHJhL2kyLzIyMDE0ODQ2MDI0NDcvTzFDTjAxVmNJNHI1MVR3bG5UcTU2Ym5fISEyMjAxNDg0NjAyNDQ3LmpwZyIgYWxpZ249ImFic21pZGRsZSI+PC9wPg==
Продавец:香菜味可店
Рейтинг:

Всего отзывов:0
Положительных:0
Выберите вариацию / цвет




- Собирать и покупать
- Приоритетная доставка




Добавить в корзину
- Информация о товаре
- Фотографии
| Цвет: | Черный силиконовый комплект, 7 шт, Черный антибактериальный комплект, 7 шт, Красный силиконовый комплект, 7 шт, Красный антибактериальный комплект, 7 шт, Black Five -Piece Set (American Standard Series), Red Five -Piece Set (American Standard Series), Черный семерым набор (Стандартная серия ЕС), Красная семи -куча (Стандартная серия ЕС), Собирать и покупать, Приоритетная доставка |